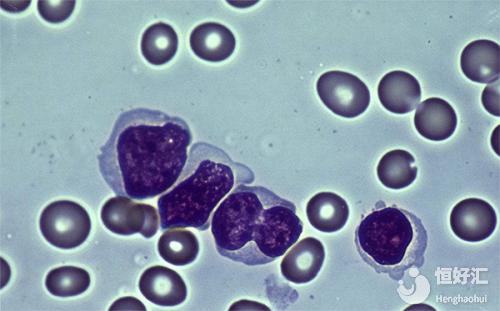

自從試管嬰兒的應用越來越廣泛之后,隨即而來的也有各種各樣的謠言,有些地區甚至覺得試管嬰兒技術生出的孩子是“怪物”。正是因為這些謠言存在,所以很多家庭即使做了試管,也會當成是家族的秘密,覺得這樣很丟臉。
但要知道,如果夫妻雙方一年內不采取任何措施同房,然后后面都沒有懷孕,這種情況就屬于不孕不育癥。而對于不孕不育,目前試管嬰兒技術就是最好的應對方法。
前面也說過,試管嬰兒技術存在很多謠言,其中就包括做試管容易患上白血病。對于這個說法,更讓很多夫妻緊張萬分,那么事實是不是真是這樣呢?做試管嬰兒真的容易得白血病嗎?
根據生殖專家介紹,試管嬰兒是一種輔助生殖技術,在患者無法實現自然懷孕的情況下,只要滿足要求就都可以選擇做試管嬰兒助孕。試管嬰兒主要是采用人工方式將精子、卵子取出,然后在實驗室培養胚胎,最后將健康的胚胎移植到子宮內。
試管嬰兒主要是幫助不孕患者實現生育的一項生殖技術,除了受精方式不一樣之外,其妊娠過程與普通懷孕沒有什么區別。
而對于做試管嬰兒容易得白血病的說法,據專家認為,其實這個并沒有科學依據。因為白血病算是發病率比較高的疾病,并不是因為做試管嬰兒才受到影響。雖然說試管嬰兒同樣也遺傳父母的基因,但它并不是白血病的主要來源。做試管嬰兒得白血病的因素主要有以下幾點:1、遺傳白血病與遺傳有很大的關系,根據相關數據顯示,在白血病患者中,有其中8.1%的患者是家族遺傳,而近親結婚的發生率更高。
2、病毒對于白血病,其實也不能忽視病毒,因為病毒感染也會導致腫瘤基因激活,從而成為惡性轉變基因,更會導致靶細胞惡變。如果病毒改變了正常功能,后期也有可能會引起白血病。
3、放射性電離輻射會導致白血病發生,這個說法已經得到了證實。患有白血病主要是與放射劑量大小、輻射部位有關。如果骨髓受到放射輻射,后期很容易出現白血病。
看到這里,相信大家也知道白血病與試管嬰兒技術并沒有直接關系,反而與以上因素有很大的關聯。所以,大家不要過于相信網上的謠言,這樣只會影響治療進程,進而影響成功率。